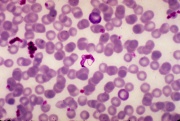

Dateiliste
Zur Navigation springen
Zur Suche springen
Diese Spezialseite listet alle hochgeladenen Dateien auf.
| Datum | Name | Vorschaubild | Größe | Benutzer | Beschreibung | Versionen |
|---|---|---|---|---|---|---|
| 06:50, 26. Feb. 2022 | Cc.logo.circle.svg (Datei) |  |
1 KB | Maintenance script | (recovered file, missing upload log entry) | 1 |
| 06:50, 26. Feb. 2022 | Chagas-2.jpg (Datei) | |
119 KB | Maintenance script | (recovered file, missing upload log entry) | 1 |
| 06:50, 26. Feb. 2022 | CheckUser1de.png (Datei) |  |
40 KB | Maintenance script | (recovered file, missing upload log entry) | 1 |
| 06:50, 26. Feb. 2022 | Chiquadrat test01.jpg (Datei) | 10 KB | Maintenance script | (recovered file, missing upload log entry) | 1 | |
| 06:50, 26. Feb. 2022 | Chiquadrat test kxl.jpg (Datei) |  |
7 KB | Maintenance script | (recovered file, missing upload log entry) | 1 |
| 06:50, 26. Feb. 2022 | Christina Koehlen01.jpg (Datei) |  |
28 KB | Maintenance script | (recovered file, missing upload log entry) | 1 |
| 06:50, 26. Feb. 2022 | Cortison.jpg (Datei) |  |
33 KB | Maintenance script | (recovered file, missing upload log entry) | 1 |
| 06:50, 26. Feb. 2022 | Crohn Jejunum.png (Datei) |  |
300 KB | Maintenance script | (recovered file, missing upload log entry) | 1 |
| 06:50, 26. Feb. 2022 | Crossing over 01.jpg (Datei) |  |
68 KB | Maintenance script | (recovered file, missing upload log entry) | 1 |
| 06:50, 26. Feb. 2022 | DRGFormat.png (Datei) |  |
5 KB | Maintenance script | (recovered file, missing upload log entry) | 1 |
| 06:50, 26. Feb. 2022 | Damec.jpg (Datei) |  |
21 KB | Maintenance script | (recovered file, missing upload log entry) | 1 |
| 06:50, 26. Feb. 2022 | Darmgeraeusche001.jpg (Datei) |  |
9 KB | Maintenance script | (recovered file, missing upload log entry) | 1 |
| 06:50, 26. Feb. 2022 | De-recentchanges.png (Datei) |  |
11 KB | Maintenance script | (recovered file, missing upload log entry) | 1 |
| 06:50, 26. Feb. 2022 | Defib electrode placement.JPG (Datei) |  |
10 KB | Maintenance script | (recovered file, missing upload log entry) | 1 |
| 06:50, 26. Feb. 2022 | Dickdarm.gif (Datei) |  |
3 KB | Maintenance script | (recovered file, missing upload log entry) | 1 |
| 06:50, 26. Feb. 2022 | Dokumentation School Health nurse.JPG (Datei) |  |
288 KB | Maintenance script | (recovered file, missing upload log entry) | 1 |
| 06:50, 26. Feb. 2022 | Dreiwegehahn 5.JPG (Datei) |  |
348 KB | Maintenance script | (recovered file, missing upload log entry) | 1 |
| 06:50, 26. Feb. 2022 | Druckkontrolle.jpg (Datei) |  |
473 KB | Maintenance script | (recovered file, missing upload log entry) | 1 |
| 06:50, 26. Feb. 2022 | Durchlaufregler.JPG (Datei) |  |
357 KB | Maintenance script | (recovered file, missing upload log entry) | 1 |
| 06:50, 26. Feb. 2022 | EKG Asystole 01.jpg (Datei) |  |
14 KB | Maintenance script | (recovered file, missing upload log entry) | 1 |
| 06:50, 26. Feb. 2022 | EKG Kammerflimmern 01.jpg (Datei) |  |
46 KB | Maintenance script | (recovered file, missing upload log entry) | 1 |
| 06:50, 26. Feb. 2022 | EKG Kammertachykardie 01.jpg (Datei) |  |
52 KB | Maintenance script | (recovered file, missing upload log entry) | 1 |
| 06:50, 26. Feb. 2022 | EKG weak action 1.jpg (Datei) |  |
21 KB | Maintenance script | (recovered file, missing upload log entry) | 1 |
| 06:50, 26. Feb. 2022 | E coli.jpg (Datei) |  |
165 KB | Maintenance script | (recovered file, missing upload log entry) | 1 |
| 06:50, 26. Feb. 2022 | Einflussfaktoren Bsp1.jpg (Datei) |  |
24 KB | Maintenance script | (recovered file, missing upload log entry) | 1 |
| 06:50, 26. Feb. 2022 | Einschraenkungen.gif (Datei) |  |
15 KB | Maintenance script | (recovered file, missing upload log entry) | 1 |
| 06:50, 26. Feb. 2022 | Einwegspritze01.jpg (Datei) |  |
98 KB | Maintenance script | (recovered file, missing upload log entry) | 1 |
| 06:50, 26. Feb. 2022 | Einwilligungsvorbehalte.gif (Datei) |  |
18 KB | Maintenance script | (recovered file, missing upload log entry) | 1 |
| 06:50, 26. Feb. 2022 | Einwilligungsvorbehalte2001 2007.gif (Datei) |  |
27 KB | Maintenance script | (recovered file, missing upload log entry) | 1 |
| 06:50, 26. Feb. 2022 | Elektrische Kerze aus Silikon (Abschiedskiste).JPG (Datei) |  |
1,08 MB | Maintenance script | (recovered file, missing upload log entry) | 1 |
| 06:50, 26. Feb. 2022 | Engelstrompete.jpg (Datei) |  |
48 KB | Maintenance script | (recovered file, missing upload log entry) | 1 |
| 06:50, 26. Feb. 2022 | Entruempelung.jpg (Datei) |  |
16 KB | Maintenance script | (recovered file, missing upload log entry) | 1 |
| 06:50, 26. Feb. 2022 | EpigastrischerW.jpg (Datei) |  |
108 KB | Maintenance script | (recovered file, missing upload log entry) | 1 |
| 06:50, 26. Feb. 2022 | Erstehilfe.jpg (Datei) |  |
13 KB | Maintenance script | (recovered file, missing upload log entry) | 1 |
| 06:50, 26. Feb. 2022 | Erweiterungen.gif (Datei) |  |
19 KB | Maintenance script | (recovered file, missing upload log entry) | 1 |
| 06:50, 26. Feb. 2022 | Evers.jpg (Datei) |  |
7 KB | Maintenance script | (recovered file, missing upload log entry) | 1 |
| 06:50, 26. Feb. 2022 | Expertenbörse Pflege 08 Pflegewiki Interview.JPG (Datei) |  |
614 KB | Maintenance script | (recovered file, missing upload log entry) | 1 |
| 06:50, 26. Feb. 2022 | FIEBERintermittierend0.gif (Datei) |  |
5 KB | Maintenance script | (recovered file, missing upload log entry) | 1 |
| 06:50, 26. Feb. 2022 | FIEBERkontinuierlich1.gif (Datei) |  |
4 KB | Maintenance script | (recovered file, missing upload log entry) | 1 |
| 06:50, 26. Feb. 2022 | FIEBERrekurrierend.gif (Datei) |  |
4 KB | Maintenance script | (recovered file, missing upload log entry) | 1 |
| 06:50, 26. Feb. 2022 | FIEBERremittierend7.gif (Datei) |  |
4 KB | Maintenance script | (recovered file, missing upload log entry) | 1 |
| 06:50, 26. Feb. 2022 | FIEBERundulierend8.gif (Datei) |  |
4 KB | Maintenance script | (recovered file, missing upload log entry) | 1 |
| 06:50, 26. Feb. 2022 | Fahrtkosten.jpg (Datei) |  |
6 KB | Maintenance script | (recovered file, missing upload log entry) | 1 |
| 06:50, 26. Feb. 2022 | Feuchtbeatmung Befeuchter.jpg (Datei) |  |
1,15 MB | Maintenance script | (recovered file, missing upload log entry) | 1 |
| 06:50, 26. Feb. 2022 | Filzlaus.gif (Datei) |  |
4 KB | Maintenance script | (recovered file, missing upload log entry) | 1 |
| 06:50, 26. Feb. 2022 | Fingertip.JPG (Datei) |  |
357 KB | Maintenance script | (recovered file, missing upload log entry) | 1 |
| 06:50, 26. Feb. 2022 | Fixierung.jpg (Datei) |  |
4 KB | Maintenance script | (recovered file, missing upload log entry) | 1 |
| 06:50, 26. Feb. 2022 | Flag of Switzerland.jpg (Datei) |  |
6 KB | Maintenance script | (recovered file, missing upload log entry) | 1 |
| 06:50, 26. Feb. 2022 | Flasche Muttermilch01.jpg (Datei) |  |
466 KB | Maintenance script | (recovered file, missing upload log entry) | 1 |
| 06:50, 26. Feb. 2022 | Flohsamen.JPG (Datei) |  |
350 KB | Maintenance script | (recovered file, missing upload log entry) | 1 |